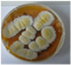
Pathogens 11 01171 i002
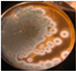
Pathogens 11 01171 i007
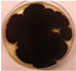
Pathogens 11 01171 i009
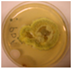
Pathogens 11 01171 i011
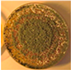
Pathogens 11 01171 i017
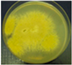
Pathogens 11 01171 i023
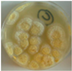
Pathogens 11 01171 i029
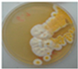
Pathogens 11 01171 i031
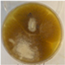
Pathogens 11 01171 i037
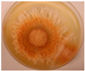
Pathogens 11 01171 i041
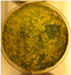
Pathogens 11 01171 i049
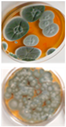
Pathogens 11 01171 i051

Aspergillus Was the Dominant Genus Found during Diversity Tracking of Potentially Pathogenic Indoor Fungal Isolates
Abstract
1. Introduction
2. Results
2.1. Fungal Isolates Screened Positive for Pathogenic Potential
2.2. Identification of Potentially Pathogenic Strains to the Species Level
2.3. Occurrence of Pathogenic Isolates in Moldy Problematic and Non-Problematic Ordinary Buildings
2.4. Characterization of Two Representants of the Major Pathogenic Genus: Aspergillus niger and Aspergillus calidodustus
2.4.1. Effect of Genapol-X-080 on the Competitiveness of the Aspergillus niger Strain Asp21 during 21 d of Incubation on Solid Culture Medium
2.4.2. Effects of Two Biocides and a Tenside on the Germination of Conidia, Resporulation and Production of Hülle Cells in an Exposed Aspergillus calidoustus Strain
3. Discussion
3.1. Detecting Indoor Fungi Exhibiting Pathogenic Potential by Screening for Growth in Neutral pH
3.2. Identification to Species Level of Potentially Pathogenic Indoor Isolates Assigned to Risk Group 1 and 2 Organisms
3.3. Strains of Paecilomyces Representing Possible New Species of Potentially Pathogenic Fungi
3.4. The Aspergillus Species in Buildings May Adapt to Biocides and Cleaning Chemicals
4. Conclusions
5. Materials and Methods
5.1. Experimental Design
5.2. Strain Collection of 284 Fungal Isolates from 20 Buildings
5.3. Determination of Morphotypes
5.4. Screening for Pathogenic Potential
5.5. HPLC-MS Analysis and Identification of Mycotoxins
5.6. Identification of the Potential Fungal Opportunistic Pathogens to the Species Level
5.7. Testing the Effects of Biocides and a Tenside on an Aspergillus calidoustus Strain
5.8. Testing Genapol-X-080 on the Competitiveness of an Aspergillus niger Strain
Author Contributions
Funding
Institutional Review Board Statement
Informed Consent Statement
Data Availability Statement
Acknowledgments
Conflicts of Interest
References
- Gniadek, A.; Macura, A.B. Intensive care unit environment contamination with fungi. Adv. Med. Sci. 2007, 52, 283–287. [Google Scholar] [PubMed]
- Siqueira, J.P.Z.; Sutton, D.A.; Gené, J.; García, D.; Wiederhold, N.; Guarro, J. Species of Aspergillus section Aspergillus from clinical samples in the United States. Med. Mycol. 2018, 56, 541–550. [Google Scholar] [CrossRef] [PubMed]
- Paulussen, C.; Hallsworth, J.E.; Álvarez-Pérez, S.; Nierman, W.C.; Hamill, P.G.; Blain, D.; Rediers, H.; Lievens, B. Ecology of aspergillosis: Insights into the pathogenic potency of Aspergillus fumigatus and some other Aspergillus species. Microb. Biotechnol. 2017, 10, 296–322. [Google Scholar] [CrossRef] [PubMed]
- Fogle, M.R.; Douglas, D.R.; Jumper, C.A.; Straus, D.C. Growth and mycotoxin production by Chaetomium globosum is favored in a neutral pH. Int. J. Mol. Sci. 2008, 12, 2357–2365. [Google Scholar] [CrossRef] [PubMed]
- Kumar, A.; Ritu, S.; Joshi, S.; Misra, A. Mucormycosis in COVID-19: A systematic review of cases reported worldwide and in India. Diabetes Metab. Syndr. 2021, 15, 102146. [Google Scholar] [CrossRef]
- Monika, P.; Chandraprabha, M.N. Risks of mucormycosis in the current COVID 19 pandemic: A clinical challenge in both immunocompromised and immunocompetent patients. Mol. Biol. Rep. 2022, 49, 4977–4988. [Google Scholar] [CrossRef] [PubMed]
- Kredics, L.; Antal, Z.; Dóczi, I.; Manczinger, L.; Kevei, F.; Nagy, E. Clinical importance of the genus Trichoderma. A review. Acta Microbiol. Immunol. Hung. 2003, 50, 105–117. [Google Scholar] [CrossRef]
- Naeimi, S.; Hatvani, L.; Marik, T.; Balázs, D.; Dóczi, I.; Cai, F.; Vágvölgyi, C.; Druzhinina, I.S.; Kredics, L. Trichodermosis: Human infections caused by Trichoderma species. In Advances in Trichoderma Biology for Agricultural Applications; Amaresan, N., Sankaranarayanan, A., Dwivedi, M.K., Druzhinina, I.S., Eds.; Fungal Biology; Springer: Cham, Switzerland, 2022; pp. 607–634. [Google Scholar] [CrossRef]
- Sandoval-Denis, M.; Sutton, D.A.; Cano-Lira, J.F.; Gené, J.; Fothergill, A.W.; Wiederhold, N.P.; Guarro, J. Phylogeny of the clinically relevant species of the emerging fungus Trichoderma and their antifungal susceptibilities. J. Clin. Microbiol. 2014, 52, 2112–2125. [Google Scholar] [CrossRef]
- Andersen, B.; Frisvad, J.C.; Dunn, R.R.; Thrane, U. A Pilot Study on Baseline Fungi and Moisture Indicator Fungi in Danish Homes. J. Fungi 2021, 7, 71. [Google Scholar] [CrossRef]
- Dichtl, K.; Samantaray, S.; Wagener, J. Cell wall integrity signalling in human pathogenic fungi. Cell. Microbiol. 2016, 8, 1228–1238. [Google Scholar] [CrossRef]
- Mousavi, B.; Hedayati, M.T.; Hedayati, N.; Ilkit, M.; Syedmousavi, S. Aspergillus species in indoor environments and their possible occupational and public health hazards. Med. Mycol. 2016, 2, 36–42. [Google Scholar] [CrossRef] [PubMed]
- Glampedakis, E.; Erard, V.; Lamoth, F. Clinical relevance and characteristics of Aspergillus calidoustus and other Aspergillus species of Section Usti. J. Fungi 2020, 6, 84. [Google Scholar] [CrossRef]
- Kim, D.M.; Lee, M.H.; Suh, M.K.; Ha, G.Y.; Kim, H.; Choi, J.S. Onychomycosis caused by Chaetomium globosum. Ann. Dermatol. 2013, 24, 232–236. [Google Scholar] [CrossRef] [PubMed]
- Bongomin, F.; Batac, C.; Richardson, M.; Denning, D. A review of onychomycosis due to Aspergillus species. Mycopathologia 2018, 183, 485–493. [Google Scholar] [CrossRef] [PubMed]
- Davis, D. How human pathogenic fungi sense and adapt to pH: The link to virulence. Curr. Opin. Microbiol. 2009, 12, 365–370. [Google Scholar] [CrossRef] [PubMed]
- Andersson, M.; Mikkola, R.; Salo, J.; Salonen, H. Veden pinta-aktiivisuuteen vaikuttavat aineet ja niiden vaikutukset sisäilman laatuun. In Proceedings of the Sisäilmasto seminariin, Helsinki, Finland, 15 March 2022; SYI raportti. Volume 40, pp. 281–287. [Google Scholar]
- Andersson, M.; Kredics, L.; Kedves, O.; Marik, T.; Salonen, H. Potentially pathogenic fungi in Finnish educational buildings. In Proceedings of the Sisäilmasto seminaari, Helsinki, Finland, 15 March 2022; SYI raportti. Volume 40, pp. 275–280. [Google Scholar]
- Salo, M.J.; Marik, T.; Bencsik, O.; Mikkola, R.; Kredics, L.; Szekeres, A.; Andersson, M.A.; Salonen, H.; Kurnitski, J. Screening mold colonies by using two toxicity assays revealed indoor strains of Aspergillus calidoustus producing ophiobolins G and K. Toxins 2019, 11, 683. [Google Scholar] [CrossRef] [PubMed]
- Andersson, M.A.; Salkinoja-Salonen, M.; Mikkola, R. Uusi menetelmä sisäilmatoksiinien löytämiseen: LC-MS Biotesti yhdistelmä. In Proceedings of the Sisäilmasto Seminaari, Helsinki, Finland, 16 March 2012; SYI Raportti nr. 30. pp. 37–42. [Google Scholar]
- Salo, M.J.; Marik, T.; Mikkola, R.; Andersson, M.A.; Kredics, L.; Salonen, H.; Kurnitski, J. Penicillium expansum strain isolated from indoor building material was able to grow on gypsum board and emitted guttation droplets containing chaetoglobosins and communesins A, B and D. J. Appl. Microbiol. 2019, 127, 1135–1147. [Google Scholar] [CrossRef]
- Castagnoli, E.; Marik, T.; Mikkola, R.; Kredics, L.; Andersson, M.A.; Salonen, H.; Kurnitski, J. Indoor Trichoderma strains emitting peptaibols in guttation droplets. J. Appl. Microbiol. 2018, 125, 1408–1422. [Google Scholar] [CrossRef] [PubMed]
- Vornanen-Winqvist, C.; Salonen, H.; Järvi, K.; Andersson, M.A.; Mikkola, R.; Marik, T.; Kredics, L.; Kurnitski, J. Effects of Ventilation Improvement on Measured and Perceived Indoor Air Quality in a School Building with a Hybrid Ventilation System. Int. J. Environ. Res. Public Health 2018, 15, 1414. [Google Scholar] [CrossRef]
- Mikkola, R.; Andersson, M.A.; Kredics, L.; Grigoriev, P.A.; Sundell, N.; Salkinoja-Salonen, M.S. 20-Residueand 11-residue peptaibols from the fungus Trichoderma longibrachiatum are synergistic in forming Na+/K+-permeable channels and adverse action towards mammalian cells. FEBS J. 2012, 279, 4172–4190. [Google Scholar] [CrossRef] [PubMed]
- Druzhinina, I.S.; Komon-Zelazowsa, M.; Kredics, L.; Hatvani, L.; Antal, Z.; Belayneh, T.; Kubicek, C.P. Alternative reproductive strategies of Hypocrea orientalis and genetically close but clonal Trichoderma longibrachiatum, both capable of causing invasive mycoses of humans. Microbiology 2008, 154, 3447–3459. [Google Scholar] [CrossRef]
- Kedves, O.; Kocsubé, S.; Bata, T.; Andersson, M.A.; Salo, J.M.; Mikkola, R.; Salonen, H.; Szűcs, A.; Kedves, A.; Kónya, Z.; et al. Chaetomium and Chaetomium-like species from European indoor environments include Dichotomopilus finlandicus sp. nov. Pathogens 2021, 10, 1133. [Google Scholar] [CrossRef] [PubMed]
- Salo, J.; Kedves, O.; Mikkola, R.; Kredics, L.; Andersson, M.A.; Kurnitski, J.; Salonen, H. Detection of Chaetomium globosum, Ch. cochliodes and Ch. rectangulare during the diversity tracking of mycotoxin-producing Chaetomium-like isolates obtained in buildings in Finland. Toxins 2020, 12, 443. [Google Scholar] [CrossRef]
- Mikkola, R.; Andersson, M.A.; Hautaniemi, M.; Salkinoja-Salonen, M.S. Toxic indole alkaloids avrainvillamide and stephacidin B produced by a biocide tolerant indoor mold Aspergillus westerdijkiae. Toxicon 2015, 99, 58–67. [Google Scholar] [CrossRef] [PubMed]
- Gannibal, P.B. Polyphasic approach to fungal taxonomy. Biol. Bull. Rev. 2022, 12, 18–28. [Google Scholar] [CrossRef]
- Senanayake, I.C.; Rathnayaka, A.R.; Marasinghe, D.S.; Calabon, M.S.; Gentekaki, E.; Lee, H.B.; Hurdeal, V.G.; Pem, D.; Dissanayake, L.S.; Wijesinghe, S.N.; et al. Morphological approaches in studying fungi: Collection, examination, isolation, sporulation and preservation. Mycosphere 2020, 11, 2678–2754. [Google Scholar] [CrossRef]
- Madsen, A.M.; Frederiksen, M.W.; Jacobsen, M.H.; Tendal, K. Towards a risk evaluation of workers’ exposure to handborne and airborne microbial species as exemplified with waste collection workers. Environ. Res. 2020, 183, 109177. [Google Scholar] [CrossRef]
- German Collection of Microorganisms and Cell Cultures GmbH: Catalogue (dsmz.de). Brauschweig Germany. Available online: https//dsmz.de (accessed on 6 October 2022).
- Houbraken, J.; Verweij, P.E.; Rijs, A.J.M.M.; Borman, A.M.; Samson, R.A. Identification of Paecilomyces variotii in clinical samples and settings. J. Clin. Microbiol. 2010, 48, 2754–2761. [Google Scholar] [CrossRef] [PubMed]
- Kuhls, K.; Lieckefeldt, E.; Börner, T.; Gueho, E. Molecular reidentification of human pathogenic Trichoderma isolates as Trichoderma longibrachiatum and Trichoderma citrinoviride. Med. Mycol. 1999, 37, 25–33. [Google Scholar] [CrossRef]
- Troppens, D.M.; Köhler, A.M.; Schlüter, R.; Hopper, M.; Gerke, J.; Braus, G.H. Hülle cells of Aspergillus nidulans with nuclear storage and developmental backup functions are reminiscent of multipotent stem cells. mBio 2020, 11, e01673-20. [Google Scholar] [CrossRef]
- Meade, E.; Slattery, M.A.; Garvey, M. Biocidal resistance in clinically relevant microbial species: A major public health risk. Pathogens 2021, 10, 598. [Google Scholar] [CrossRef] [PubMed]
- Araujo, G.; de Souza, W.; Frases, S. The hidden pathogenic potential of pathogenic fungi. Future Microbiol. 2017, 12, 1533–1540. [Google Scholar] [CrossRef] [PubMed]
- Shams-Ghahfarokhi, M.; Aghaei-Gharehbolagh, S.; Aslani, N.; Razzaghi-Abyaneh, M. Investigation on distribution of airborne fungi in outdoor environment in Tehran, Iran. J. Environ. Health Sci. Eng. 2014, 12, 54. [Google Scholar] [CrossRef] [PubMed]
- Rook, G.; Bloomfield, S. Microbial exposures that establish immunoregulation are compatible with targeted hygiene. J. Allergy Clin. Immunol. 2021, 148, 33–39. [Google Scholar] [CrossRef]
- Houbraken, J.; Samson, R.A. Phylogeny of Penicillium and the segregation of Trichocomaceae into three families. Stud. Mycol. 2011, 70, 1–51. [Google Scholar] [CrossRef]
- Houbraken, J.; Kocsubé, S.; Visagie, C.M.; Yilmaz, N.; Wang, X.-C.; Meijer, M.; Kraak, B.; Hubka, V.; Bensch, K.; Samson, R.A.; et al. Classification of Aspergillus, Penicillium, Talaromyces and related genera (Eurotiales): An overview of families, genera, subgenera, sections, series and species. Stud. Mycol. 2020, 95, 5–169. [Google Scholar] [CrossRef]
- Walther, G.; Pawlowska, J.; Alastruey-Izquierdo, A.; Wrzosek, M.; Rodriguez-Tudela, J.L.; Dolatabadi, S.; Chakrabarti, A.; de Hoog, G.S. DNA barcoding in Mucorales: An inventory of biodiversity. Persoonia 2013, 30, 11–47. [Google Scholar] [CrossRef]
- Kuhls, K.; Lieckfeldt, E.; Samuels, G.J.; Kovacs, W.; Meyer, W.; Petrini, O.; Gams, W.; Borner, T.; Kubicek, C.P. Molecular evidence that the asexual industrial fungus Trichoderma reesei is a clonal derivative of the ascomycete Hypocrea jecorina. Proc. Natl. Acad. Sci. USA 1996, 93, 7755–7760. [Google Scholar] [CrossRef]
- Wang, X.W.; Lombard, L.; Groenewald, J.Z.; Li, J.; Videira, S.I.; Samson, R.A.; Liu, X.Z.; Crous, P.W. Phylogenetic reassessment of the Chaetomium globosum species complex. Persoonia 2016, 36, 83–133. [Google Scholar] [CrossRef]



| Morphology Microscopy (M) Colony MEA (C) Fluorescence of Cell Dispersal (F) | Growth at 37 °C pH 7.2 | Toxicity Profile | Conidiospore/Sporangiospore Size in µm, Hülle Cells | From Problematic/Ordinary Building P/O | ||||
|---|---|---|---|---|---|---|---|---|
| M | C | F | BMSI | ICP | P | O | ||
| A. Isolates with high pathogenic potential (growing well at 37 °C in pH 7.2) | ||||||||
| 1. Genus Aspergillus | ||||||||
| MT1 (5 strains) | ||||||||
![]() | ![]() | ++ | + | + | 3–4![]() | + | - | |
| MT2 (1strain) | ||||||||
![]() | ![]() | ++ | + | + | 3–4 | + | - | |
| MT3 (5 strains) | ||||||||
![]() | ![]() | ++ | - | + | 2–3 | + | + | |
| MT4 (21 strains) | ||||||||
![]() | ![]() | ++ | - | + | 4–5 | + | + | |
| MT5 (2 strains) | ||||||||
![]() | ![]() | ++ | + | + | 5 × 8 | + | -- | |
| MT6 (10 strains) | ||||||||
![]() | ![]() | ++ | - | - | 5–8 | + | + | |
| 2. Genus Rhizopus | ||||||||
| MT7 (4 strains) | ||||||||
![]() | ![]() | ++ | - | - | 8–10 | + | - | |
| 3. Genus Trichoderma | ||||||||
| MT8 (6 strains) | ||||||||
![]() | ![]() | ++ | + | + | 2 × 4 | + | - | |
| B. Isolates with moderate pathogenic potential (weak growth at 37 °C and pH 7.2) | ||||||||
| 1. Genus Aspergillus | ||||||||
| MT9 (1 strain) | ||||||||
![]() | ![]() | + | - | 4–5 | - | + | ||
| 2. Genus Paecilomyces | ||||||||
| MT10 (3 strains) Toxigenic isolates | ||||||||
![]() | ![]() | + | + | - | 3 × 8 | + | - | |
| MT11 (2 strains) Toxigenic isolates | ||||||||
![]() | ![]() | + | - | + | 3 × 8 | + | - | |
| MT12 (2 strains) Non-toxigenic Paecilomyces | ||||||||
![]() | ![]() | + | - | - | 3 × 8 | + | - | |
| 3. Toxigenic Trichoderma | ||||||||
| MT13 (5 strains) | ||||||||
![]() | ![]() | +* | + | + | 1.5 × 3 | + | - | |
| C. Isolates with less likely pathogenic potential (not growing at 37 °C, but growing at 30 °C at pH 7.2) | ||||||||
| 1. Toxigenic Aspergillus | ||||||||
| MT14 (12 strains) | ||||||||
![]() | ![]() | ± | + | + | 3-–4 | + | + | |
| MT15 (12 strains) | ||||||||
![]() | ![]() | ± | - | + | 3–4 | + | - | |
| 2. Toxigenic Chaetomium-like strains | ||||||||
| MT16 (10 strains) | ||||||||
![]() | ![]() | ± | + | + | 9–10 | + | + | |
| MT17 (4 strains) | ||||||||
![]() | ![]() | ± | + | + | 8 × 9 | + | - | |
| MT18 (6 strains) | ||||||||
![]() | ![]() | ± | - | + | 5 × 11 | + | - | |
| MT19 (3 strains) | ||||||||
![]() | ![]() | ± | (+) | - | 4 × 6 | + | + | |
| D. Isolates with no pathogenic potential (not growing at 37 °C and/or not growing at pH 7.2 at 30 °C) | ||||||||
| 1. Toxigenic Acrostalagmus | ||||||||
| MT20 (8 strains) | ||||||||
![]() | ![]() | - | - | + | 3 × 5 | + | - | |
| 2. Toxigenic Penicillium | ||||||||
| MT21 (8 strains | ||||||||
![]() | ![]() | - | - | + | 3–4 | + | + | |
| MT22 (10 strains) | ||||||||
![]() | ![]() | - | - | + | 3–4 | + | + | |
| MT23 (6 strains) | ||||||||
![]() | ![]() | - | + | + | 3–4 | + | - | |
| 3. Toxigenic Trichoderma | ||||||||
| MT24 (40 strains) | ||||||||
![]() | ![]() | - ** | + | + | 3–5 | + | - | |
| 4. Non-toxic Penicillium | ||||||||
| MT25 (63 strains) | ||||||||
![]() | ![]() | ![]() | - | - | - | 3–5 | + | + |
| 5. Non-toxic Rhizopus | ||||||||
| MT26 (35 strains) | ||||||||
![]() | ![]() | - | - | - | 8–10 | + | + | |
| Morphotype | Species | Strain ID | Location of Isolation | GenBank Accession Number | |||||
|---|---|---|---|---|---|---|---|---|---|
| Toxin/Metabolite | tef1α | ITS | rpb2 | CaM | Ref. | ||||
| MT1 | Aspergillus calidoustus | MH4 | Indoor settled dust, university office, Finland | Ophiobolins | KM853016 | [19] | |||
| Aspergillus calidoustus | MH21 | Indoor settled dust, university office, Finland | ND | [19] | |||||
| Aspergillus calidoustus | MH34 | Indoor settled dust, university office, Finland | ND | [19] | |||||
| Aspergillus calidoustus | MH36 | Indoor settled dust, university office, Finland | ND | [19] | |||||
| MT2 | Aspergillus calidoustus | Asp16/LKK | Indoor dust, school, Finland | Ophiobolin K Ophiobolin G | OP356693 | recent study 1 | |||
| MT3 | Aspergillus fumigatus | AE1 | Indoor settled dust, gym, Finland | ND | OP295388 | recent study | |||
| Aspergillus fumigatus | AE5 | Indoor settled dust, gym, Finland | ND | OP295389 | recent study | ||||
| Aspergillus fumigatus | AH3 | Indoor settled dust, gym, Finland | ND | OP295390 | recent study | ||||
| MT4 | Aspergillus niger | Asp21 | Exhaust filter school Finland | ND | OP356697 | recent study | |||
| Aspergillus niger | Asp1 | Exhaust filter, school, Finland | ND | OP295392 | recent study | ||||
| Aspergillus niger | AE4 | Indoor settled dust gym Finland | ND | OP295391 | recent study | ||||
| Aspergillus tubingensis | Asp2 | Exhaust filter school Finland | ND | OP295394 | recent study | ||||
| Aspergillus tubingensis | ASN | Indoor settled dust gym Finland | ND | OP295393 | recent study | ||||
| MT5 | Aspergillus pseudoglaucus | 8/SL | Fall out plate appartment Finland | ND | OP356700 | recent study | |||
| MT6 | Aspergillus flavus | 7D | Extract filter school Finland | ND | OP356699 | recent study | |||
| Aspergillus flavus | 1/37 | Extract filter school Finland | ND | OP356698 | recent study | ||||
| Aspergillus flavus | AGE | Indoor settled dust gym Finland | ND | OP295387 | recent study | ||||
| Aspergillus flavus | AE2 | Indoor settled dust gym Finland | ND | OP295385 | recent study | ||||
| Aspergillus flavus | AEH | Indoor settled dust gym Finland | ND | OP295386 | recent study | ||||
| MT9 | A. flavus | ASpf | Indoor settled dust gym Finland | ND | OP356696 | recent study | |||
| MT10 | Paecilomyces variotii | Paec2/kop = Pa/2 = Paec2 = HAMBI 3342 * | Indoor settled dust, university, Denmark | Viriditoxin | [20,21] | ||||
| Paecilomyces variotii | Paec1/kop * | Indoor settled dust, university, Denmark | DSMZ | recent study | |||||
| MT11 | Paecilomyces sp. | ST28 | Settled dust, school, Finland | ND | OP356689 | OP295396 | recent study | ||
| Paecilomyces sp. | ST32 | Settled dust, school, Finland | ND | OP356690 | KP889008 | recent study | |||
| MT12 | Paecilomyces sp. | Pec/hiss | Settled dust, university, Finland | ND | OP356695 | recent study | |||
| Paecilomyces sp. | Pec/skk | Extract air filter, school, Finland | ND | OP356694 | recent study | ||||
| MT7 | Rhizopus arrhizus | M1/KI | Extract air filter, school Finland | ND | OP288193 | recent study | |||
| MT13 | Trichoderma citrinoviride | SJ40 | Settled dust, office, Espoo, Finland | Trilongins | MH177004 | KP889007 | [22] | ||
| Trichoderma citrinoviride | T4//LKK | Dust, school, Finland | ND | OP351639 | [23] | ||||
| MT8 | Trichoderma longibrachiatum | T37/skk | Extract air filter, school, Finland | ND | OP345956 | recent study | |||
| Trichoderma longibrachiatum | Thb | Moisture-damaged residence, Finland | Trilongins | HQ593512 | [24] | ||||
| Trichoderma longibrachiatum | Thd | Moisture-damaged residence, Finland | Trilongins | HQ593513 | [24] | ||||
| Trichoderma longibrachiatum | Thg | Moisture-damaged residence, Finland | Trilongins | EU401624 | EU401573 | EU401492 | [24,25] | ||
| MT14 | Aspergillus westerdijkiae | PP2 * | Vacuum cleaner dust, apartment, Finland | Stephacidin Avrainvillamide Ochratoxin | [24] | ||||
| Aspergillus westerdijkiae | KaIII * | Fall out plate, kindergarten, Finland | Stephacidin Avrainvillamide | [24] | |||||
| Aspergillus westerdijkiae | PP31 * | Vacum cleaner dust, apartment, Finland | ND | [24] | |||||
| Aspergillus westerdijkiae | PP3 * | Vacum cleaner dust, apartment, Finland | ND | [24] | |||||
| Aspergillus westerdijkiae | PP31 * | Vacum cleaner dust, apartment, Finland | ND | [24] | |||||
| MT15 | Aspergillus versicolor | SL/3 * | Settled dust, university office, Finland | Averufin Sterigmatocystin 5-Methoxysterigmatocystin | recent study 1 | ||||
| Aspergillus versicolor | GAS226 * | Settled dust, office, Finland | Averufin Sterigmatocystin 5-Methoxysterigmatocystin | recent study 1 | |||||
| Aspergillus versicolor | K20 | Settled dust, university Finland | Sterigmatocystin | [19] | |||||
| Aspergillus versicolor ** | MH10 | Settled dust, university Finland | ND | [19] | |||||
| Aspergillus versicolor ** | MH11 | Settled dust, university Finland | ND | [19] | |||||
| Aspergillus versicolor ** | MH25 | Settled dust, university Finland | ND | [19] | |||||
| Aspergillus versicolor ** | MH26 | Settled dust, university Finland | ND | [19] | |||||
| Aspergillus versicolor ** | MH32 | Settled dust, university Finland | ND | [9] | |||||
| Aspergillus versicolor ** | MH33 | Settled dust, university Finland | ND | [9] | |||||
| Aspergillus versicolor ** | MH35 | Settled dust, university Finland | ND | [19] | |||||
| MT16 | Chaetomium globosum | C13/LM | Exhaust air filter, school, Finland | ND | MW556666 | [26] | |||
| Chaetomium globosum1 | C22/LM | Exhaust air filter, school, | Chaetoglobosin Chaetoviridin A Chaetomugilin D Chaetoviridin C | MT498109 | recent study 1 | ||||
| Chaetomium globosum | MH5 | Settled dust, public building, Finland | Chaetoglobosin Chaetoviridin A Chaetoviridin C | MT498108 | [26] | ||||
| Chaetomium globosum | MÖ9 | Settled dust, piggery, Finland | ND | MT498106 | MW541924 | [26] | |||
| Chaetomium globosum | 2c/26 | Settled dust, apartment, Finland | ND | MW310244 | [26] | ||||
| Chaetomium globosum | 2b/26 | Settled dust, apartment, Finland | ND | MT498110 | [26] | ||||
| Chaetomium globosum | C22 | Settled dust, apartment, Finland | ND | MW556668 | [26] | ||||
| Chaetomium globosum | MH52 | Settled dust, public building, Finland | ND | MT498107 | [25] | ||||
| Chaetomium globosum | Ruk10 | Settled dust, apartment, Finland | Chaetoglobosin Chaetoviridin A Chaetoviridin C | MT498101 | MW541927 | [26,27] | |||
| Chaetomium globosum | MTAV35* | Settled dust, university, Finland | Chaetoglobosin Chaetoviridin A Chaetoviridin C | [26,27] | |||||
| Chaetomium globosum | 3b/APP | Exhaust air filter, public building, Finland | ND | MW588207 | [26] | ||||
| MT17 | Chaetomium cochliode | CH2 | Indoor stettled dust, gym Finland | Chaetomin Chaetomuglin C Chaetoviridin A | OP356691 | OP295395 | recent study 1 | ||
| Chaetomium cochliodes | CH3 | Indoor stettled dust, gym, Finland | ND | OP356692 | recent study | ||||
| Chaetomium cochliodes | OT7 | Settled dust, office, Finland | Chaetomin Chaetoviridin A Chaetomugilin D | MT498103 | [26,27] | ||||
| Chaetomium cochliodes | OT7B | Settled dust, office, Finland | Chetomin Chaetoviridin Chaetomugilin D | MT498102 | [26,27] | ||||
| MT18 | Chaetomium rectangulare | MO13 | Settled dust, piggery, Finland | ND | MT498104 MT498105 | MW541928 MW541929 | [26] | ||
| MT19 | Dichotomopilus finlandicus | Ch1/Tu | Inlet air filter, public building, Finland | ND | MT644127 | MW541926 | MZ665531 | [26,27] | |
| Dichotomopilus finlandicus | C5/LM | Exhaust air filter, school, Finland | ND | MW556671 | MW541925 | MZ665530 | [26] | ||
| Total Isolates n = 296 | Found in nr of Buildings n = 20 | Potentially Opportunistic Pathogenic and Less Likely Pathogenic isolates n = 114 | Found in nr of Buildings n = 19 | Growth at pH 7.2 | |
|---|---|---|---|---|---|
| 37 °C | 30 °C | ||||
| Aspergillus | 18 | A. calidoustus | 2 | + | + |
| A. flavus | 8 | + | + | ||
| A. fumigatus | 4 | + | + | ||
| A. niger | 18 | + | + | ||
| A. tubingensis | 2 | + | + | ||
| A. westerdijkiae | 17 | - | + | ||
| A. pseudoglaucus | 2 | + | + | ||
| A. versicolor | 6 | - | + | ||
| Chaetomium-like | 9 | C. globosum | 6 | - | + |
| C. cochliodes | 2 | - | + | ||
| C. rectangulare | 1 | - | + | ||
| D. finlandicus | 2 | - | + | ||
| Paecilomyces | 4 | Pae. variotii | 1 | + | + |
| Paecilomyces sp. | 5 | + | + | ||
| Penicillium | 20 | Pen. chrysogenum | 2 | - | |
| Rhizopus | 20 | R. arrhizus | 1 | + | + |
| Trichoderma | 10 | T. citrinoviride | 2 | + | + |
| T. longibrachiatum | 2 | + | + | ||
| T. atroviride | 10 | - | - | ||
| Number of Wells (n = 48) with Conidia Recognized by Microscopy | |||
|---|---|---|---|
| Genapol Addition | No Genapol | ||
| Plate 1 | Plate 2 | Plate 3 | |
| Paecilomyces sp. strain Pec/skk | 3 | 0 | 15 |
| Chaetomium cochliodes strain CH2 | 2 | 0 | 16 |
| A. niger strain Asp21/skk | 41 | 34 | 17 |
| No conidia | 2 | 14 | 0 |
| 1. Effects of germination of conidia after 3 d * | ||||
|---|---|---|---|---|
| Germinated conidia +++ | Germinated conidia +++ | Inactive conidia +++ | Inactive conidia +++ | |
![]() | ![]() | ![]() | ![]() | |
| Control | Genapol | Borax | Triclosan | |
| 5000 µg mL−1 | 5000 µg mL−1 | 16 µg mL−1 | ||
| 2. Effects of biocides, tenside and drying for 9 weeks * | ||||
| Inactive conidia | Hyphens | New conidia | Hülle cells | |
| µg mL−1 | ![]() | ![]() | ![]() | ![]() |
| Borax 5000 | +++ | - | - | - |
| 2500 | - | - | ++ | + |
| 1250 | - | - | ++ | + |
| Triclosan | ||||
| 16 | +++ | - | - | - |
| 8 | + | - | - | +++ |
| 4 | - | + | + | + |
| Genapol | ||||
| 5000 | - | +++ | - | - |
| 1000 | - | +++ | - | - |
| 100 | - | - | ++ | - |
| 3. Control, incubation for 9 weeks | ||||
| Inactive conidia | Hyphens | New conidia | Hülle cells | |
| Control | - | - | +++ | + |
Publisher’s Note: MDPI stays neutral with regard to jurisdictional claims in published maps and institutional affiliations. |
© 2022 by the authors. Licensee MDPI, Basel, Switzerland. This article is an open access article distributed under the terms and conditions of the Creative Commons Attribution (CC BY) license (https://creativecommons.org/licenses/by/4.0/).
Share and Cite
Andersson, M.; Varga, A.; Mikkola, R.; Vornanen-Winqvist, C.; Salo, J.; Kredics, L.; Kocsubé, S.; Salonen, H. Aspergillus Was the Dominant Genus Found during Diversity Tracking of Potentially Pathogenic Indoor Fungal Isolates. Pathogens 2022, 11, 1171. https://doi.org/10.3390/pathogens11101171
Andersson M, Varga A, Mikkola R, Vornanen-Winqvist C, Salo J, Kredics L, Kocsubé S, Salonen H. Aspergillus Was the Dominant Genus Found during Diversity Tracking of Potentially Pathogenic Indoor Fungal Isolates. Pathogens. 2022; 11(10):1171. https://doi.org/10.3390/pathogens11101171
Chicago/Turabian StyleAndersson (Aino), Maria, András Varga, Raimo Mikkola, Camilla Vornanen-Winqvist, Johanna Salo, László Kredics, Sándor Kocsubé, and Heidi Salonen. 2022. "Aspergillus Was the Dominant Genus Found during Diversity Tracking of Potentially Pathogenic Indoor Fungal Isolates" Pathogens 11, no. 10: 1171. https://doi.org/10.3390/pathogens11101171
APA StyleAndersson, M., Varga, A., Mikkola, R., Vornanen-Winqvist, C., Salo, J., Kredics, L., Kocsubé, S., & Salonen, H. (2022). Aspergillus Was the Dominant Genus Found during Diversity Tracking of Potentially Pathogenic Indoor Fungal Isolates. Pathogens, 11(10), 1171. https://doi.org/10.3390/pathogens11101171